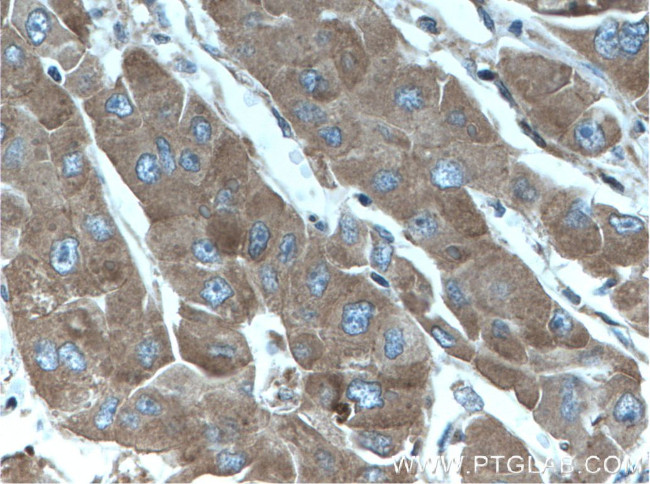
ANGPTL8 Antibody in Immunohistochemistry (Paraffin) (IHC (P))

Search
Proteintech
ANGPTL8 Monoclonal Antibody (2H9F9)
{{$productOrderCtrl.translations['antibody.pdp.commerceCard.promotion.promotions']}}
{{$productOrderCtrl.translations['antibody.pdp.commerceCard.promotion.viewpromo']}}
{{$productOrderCtrl.translations['antibody.pdp.commerceCard.promotion.promocode']}}: {{promo.promoCode}} {{promo.promoTitle}} {{promo.promoDescription}}. {{$productOrderCtrl.translations['antibody.pdp.commerceCard.promotion.learnmore']}}
产品信息
66641-1-IG
种属反应
宿主/亚型
分类
类型
克隆号
抗原
偶联物
形式
浓度
规格
纯化类型
保存液
内含物
保存条件
运输条件
产品详细信息
Immunogen sequence: RNSLGLYGR TIELLGQEVS RGRDAAQELR ASLLETQMEE DILQLQAEAT AEVLGEVAQA QKVLRDSVQR LEVQLRSAWL GPAYREFEVL KAHADKQSHI LWALTGHVQR QRREMVAQQH RLRQIQERLH TAALPA (117-251 aa encoded by BC146552)
靶标信息
The Betatrophin protein, also known as the hepatocellular carcinoma-associated protein TD26, is an adipocyte- and liver-enriched insulin targeted gene that is thought to play a role in lipid metabolism be regulating serum triglyceride levels. Betatrophin is closely related to the angiopoietin-like (ANGPTL) protein family. Betatrophin mRNA increases in the cold environment and after treatment with a high-fat diet, while its mRNA levels decrease in response to fasting, suggesting that it may play a role in mediating thermogenesis and energy homeostasis.
仅用于科研。不用于诊断过程。未经明确授权不得转售。
生物信息学
蛋白别名: Angiopoietin-like protein 8; Betatrophin; hepatocellular carcinoma-associated gene TD26; hepatocellular carcinoma-associated protein TD26; Lipasin; Refeeding-induced fat and liver protein
基因别名: ANGPTL8; C19orf80; PRO1185; PVPA599; RIFL; TD26; UNQ599/PRO1185
UniProt ID: (Human) Q6UXH0
Entrez Gene ID: (Human) 55908